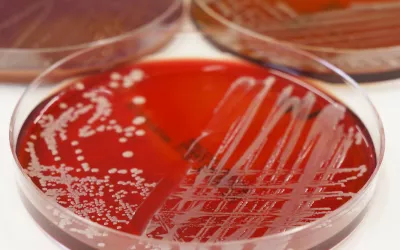
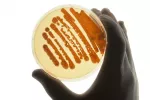

Tratamiento y prevención del carbunco o ántrax

La penicilina es el tratamiento de elección en las formas cutáneas de carbunco
Especialista en Medicina Interna del Hospital Universitario Príncipe de Asturias
Actualizado: 23 de septiembre de 2022
Cuando una persona desarrolla carbunco o ántrax el tratamiento consiste en la administración de antibióticos. En la forma cutánea suele bastar con la administración de un único fármaco por vía oral, mientras que en la afectación pulmonar o meníngea (más grave) se utilizan varios antibióticos para combatir el germen, administrándose algunos de ellos por vía intravenosa.
La penicilina es el tratamiento de elección en las formas cutáneas de carbunco. Se administra por vía oral la mayoría de las veces, aunque en los casos de mayor gravedad se puede administrar vía intramuscular o vía intravenosa. Si el enfermo es alérgico a la penicilina se pueden utilizar otros antibióticos como la doxiclina o las quinolonas. La duración del tratamiento suele ser de unos 7-10 días.
En las formas asociadas al bioterrorismo (carbunco pulmonar), dado que son muy graves y puede haber resistencia a la penicilina, se recomienda utilizar otros antibióticos como el ciprofloxacino, que se administra asociado a clindamicina. El ciprofloxacino se administra por vía intravenosa al principio, y posteriormente por vía oral. El tratamiento en estos casos puede prolongarse hasta 60 días, que es el tiempo que pueden llegar a tardar en germinar las esporas en el aparato respiratorio. Si existe afectación neurológica se añadirá al tratamiento otro antibiótico, que suele ser la rifampicina.
Prevención del carbunco o ántrax
Las medidas preventivas son fundamentales para evitar el contagio, especialmente en aquellas profesiones de riesgo. Existe además una vacuna disponible contra el Bacillus anthracis, pero ésta solo se administra a ciertas personas, como por ejemplo militares o personas que trabajan con este microorganismo en laboratorios.

En las zonas de mayor riesgo (regiones agrícolas y ganaderas) es fundamental el control de la enfermedad mediante la vacunación de los animales. Deben vacunarse anualmente todos aquellos animales susceptibles de padecer la enfermedad, fundamentalmente herbívoros como ovinos, bovinos, caprinos y equinos. Si los animales muestran síntomas de la enfermedad, se recomienda iniciar tratamiento con antibióticos.
También se pueden adoptar otras medidas como la imposición de cuarentenas o la eliminación de los animales muertos y de los materiales contaminados. En aquellas personas que por su profesión están más expuestas al contagio por B. anthracis es importante utilizar medidas de protección como son el uso de guantes o mascarillas. Así, se consigue evitar el contagio en un alto porcentaje de los casos.
La vacunación, que presenta una eficacia mayor del 90%, está indicada únicamente en aquellas personas que por su profesión presentan mayor riesgo de contagio, como son algunos veterinarios, ganaderos, o personal militar.
En aquellos sujetos que han estado expuestos al microorganismo, y que por tanto tienen riesgo de haberse contagiado, se recomienda la administración de antibióticos como ciprofloxacino durante 6-8 semanas de forma preventiva, con el objetivo de evitar la aparición de la enfermedad. Se considera que han estado expuestas a la infección las personas que hayan tomado contacto directo con el animal muerto o con sus productos, o que hayan estado en ambientes contaminados con esporas procedentes de la sangre, pelo o lana, o por consumo de animales muertos de carbunco.
En el hombre la enfermedad no se transmite por inhalación; es decir, una persona con carbunco pulmonar no puede contagiar a otras a través del estornudo o las secreciones respiratorias. Por ello, no es necesario aislamiento respiratorio. En personas que presentan lesiones cutáneas sí es necesario establecer aislamiento de contacto, ya que aunque el riesgo de contagio es bajo, sí puede darse. Finalmente, es importante descontaminar todos aquellos materiales que puedan estar contaminados por haber estado en contacto con el germen.
Creado: 21 de noviembre de 2014